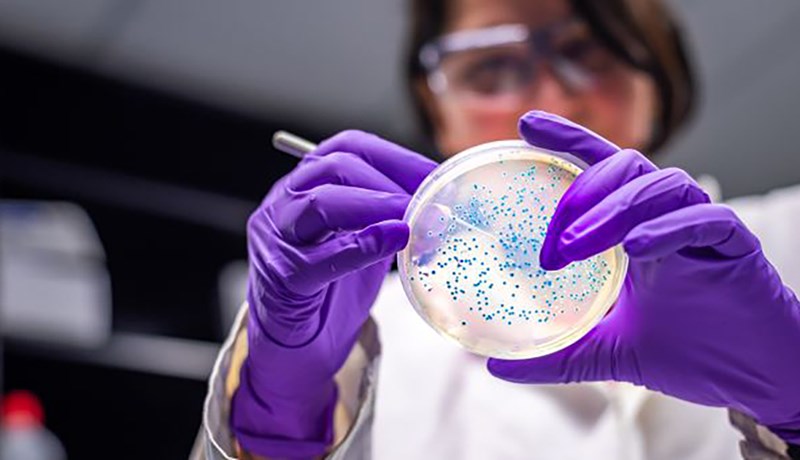
Ótti við að sýklalyfjaónæmar bakteríur verði stærra vandamál en COVID-19

Of mikið af neikvæðum fréttum
Í byrjun árs hafa Íslendingar almennt verið bjartsýnir og jákvæðir fyrir komandi ári, bjartsýni, gleði og ánægja skín almennt af öllum sem maður sér síðasta og fyrsta dag hvers árs. Því miður fannst mér þetta ekki vera svona í kringum síðustu áramót, baráttan við Covid-19 virðist vera að draga niður þá miklu bjartsýni og óskhyggju þjóðarinnar í böl...